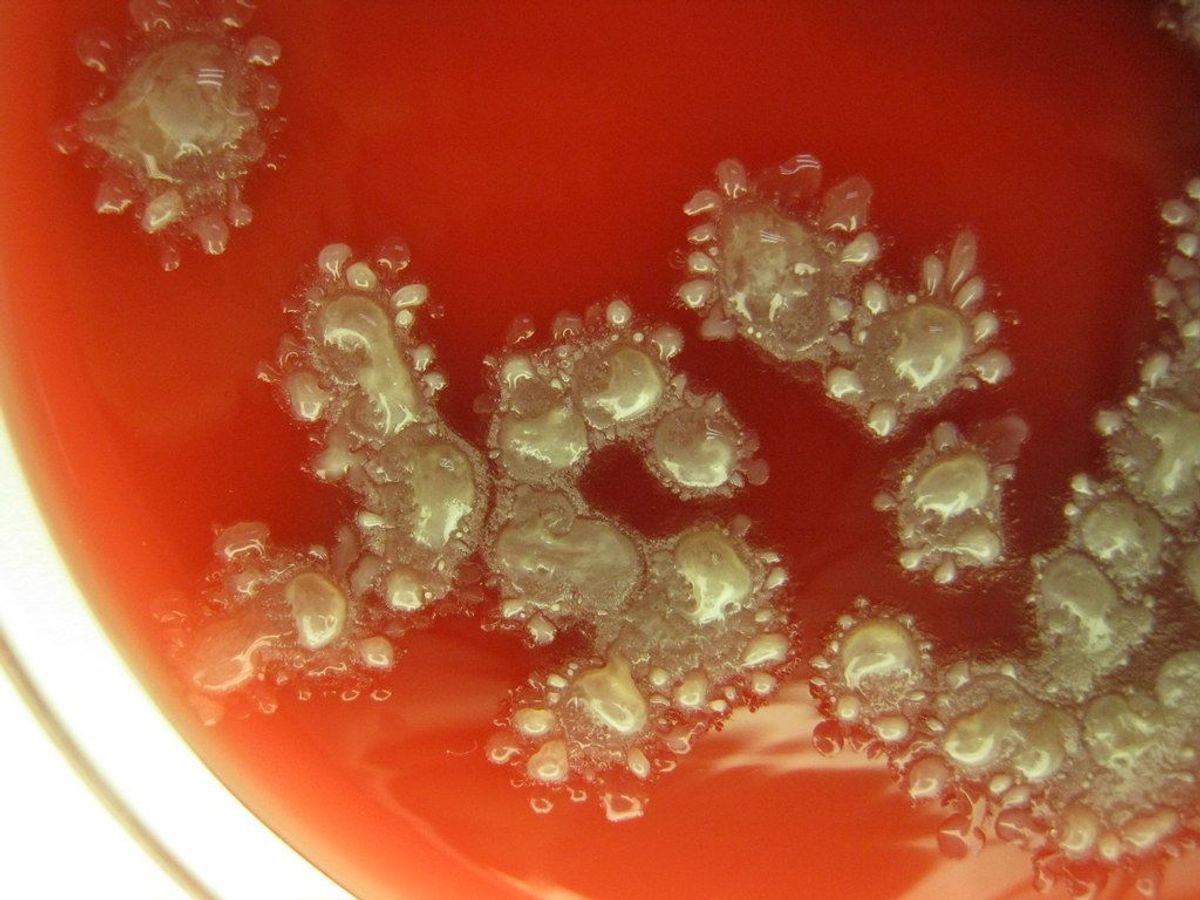

Bacillus licheniformis có khả năng tiết ra các enzym protease serine có tính kiềm cao
Chăn nuôi, thú y và nuôi trồng thủy sản: Bacillus licheniformis thường được sử dụng để cải thiện chức năng tiêu hóa, ngăn ngừa bệnh tật và thúc đẩy tăng trưởng.
Tăng cường sức khỏe vật nuôi và cải thiện môi trường chăn nuôi.
Khi được tiêu thụ trực tiếp, men vi sinh Bacillus licheniformis có thể mang lại một số lợi ích cho vật nuôi, bao gồm:
Tăng cường chức năng tiêu hóa: Bacillus licheniformis có thể tiết ra các enzym cần thiết như protease và amylase để hỗ trợ và tăng cường quá trình tiêu hóa thức ăn trong cơ thể vật nuôi. Điều này có thể cải thiện sự hấp thụ các chất dinh dưỡng trong vật nuôi và tăng hiệu quả của thức ăn.
Cân bằng hệ vi sinh vật đường ruột vật nuôi, ngăn ngừa vi khuẩn có hại và bệnh tật, nâng cao khả năng miễn dịch giúp giảm nguy cơ mắc bệnh và giảm chi phí điều trị.
Về mặt cải tạo môi trường chăn nuôi, Bacillus licheniformis thường được sử dụng trong các sản phẩm xử lý môi trường để:
Phân hủy chất thải trong môi trường, làm trong sạch môi trường sống, tạo điều kiện thuận lợi cho vật nuôi sinh trưởng và phát triển.
Giảm thiểu các chất độc hại trong môi trường nước như NH3, COD, H2S.
Men vi sinh bacillus licheniformis của Biogreen có nhiều ưu điểm vượt trội:
+ Độ tinh khiết cao.
+ Hoạt lực cao giúp tối ưu hóa hiệu quả mang lại.
+ Dạng bào chế đa dạng bao gồm cả dạng bột và dạng nước.
+ Quy cách đóng gói linh hoạt, có thể cao hoặc thấp tùy theo yêu cầu của khách hàng.
Hoạt lực:
+ Dạng bột: 1×10^9 CFU/g, 3×10^10 CFU/g.
+ Dạng dung dịch: 3×10^10 CFU/ml.
Quy cách đóng gói:
+ Dạng bột: 1 kg, 5 kg, 10 kg, 25 kg và có thể thay đổi tùy theo yêu cầu của khách hàng.
+ Dạng dung dịch: 500 ml, 1 lít, 5 lít hoặc theo yêu cầu của khách hàng.
Hạn sử dụng: 2 năm kể từ ngày sản xuất.
Bảo quản: Nơi khô ráo thoáng mát, tránh ánh sáng trực tiếp.